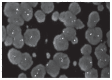

Primitive squamous cell carcinoma of the breast (SCCB): case report of an uncommon variant of metaplastic carcinoma
- PMID: 29205144
- PMCID: PMC5726501
- DOI: 10.11138/gchir/2017.38.3.139
Primitive squamous cell carcinoma of the breast (SCCB): case report of an uncommon variant of metaplastic carcinoma
Abstract
Introduction: Metaplastic carcinoma of the breast includes a heterogeneous group of neoplasms characterized by admixture of adenocarcinoma with area of squamous, chondroid and osseous differentiation. If the tumor shows pure squamous differentiation, it is designated as squamous carcinoma. SCCB accounts for less than 1% of all invasive breast carcinoma. It can present as cystic lesions and simulate a breast abscess.
Case report: A 75-year old woman was visited at our General Surgery Unit for a palpable lump, about 5 cm in size, at the lower inner quadrant of right breast. Mammography revealed 3cm oval opacity with micro calcifications and US appearance as isoechogenic lump with lesion solid-cystic appearance; cytology deposes for cystic inflammatory lesion(C2) to be monitored. A subsequent ultrasound check one year later confirmed an increase of volume, so micro histology sampling was made with suspect malignancy(B4). After biopsy, the patient underwent excision of cyst. Final histological examination showed SCCB with diffuse positivity for Cytokeratin 34beta-E12 and p63; negative reactions to ER and PR; monoclonal antibody Ki67 > 40%; HER2/neu with score 2+ and FISH examination negative. Subsequently, the patient underwent radical Madden mastectomy which confirmed the histological diagnosis and the negativity of the lymph nodes.
Discussion: In literature, prognosis and therapy are still discussed; SCCB has shown very little responsiveness to common chemotherapy.
Conclusion: A quadrantectomy or a radical mastectomy with lymph node dissection must be considered the best treatment for this rare neoplasia.
Conflict of interest statement
No conflict of interest.
Figures

References
-
- Toikkanen S. Primary squamous cell carcinoma of the breast. Cancer. 1981;48:1629–32. - PubMed
-
- Cappellani A, Di Vita M, Zanghì A, De Luca A, Tomarchio G, La Porta D, Lanzafame S, Alfano G. A pure squamous cell breast carcinoma presenting as a breast abscess: a case report and review of the literature. Ann Ital Chir. 2004;LXXV(2):259–263. - PubMed
-
- Lakani SR, Ellis IO, Schnitt SJ, Tan PH, van de Vijver MJ, editors. WHO Classification of Tumours of the Breast. Lyon: 2012.
-
- Macia M, Ces JA, Becerra E, Novo A. Pure squamous carcinoma of the breast; report of a case diagnosed by aspiration cytology. Acta Cytol. 1989;33:201–204. - PubMed
-
- Shigekawa T, Tsuda H, Sato K, Ueda S, Asakawa H, Shigenaga R, Hiraide H, Mochizuki H. Squamous cell carcinoma of the breast in the form of an intracystic tumor. Breast Cancer. 2007;14:109–112. - PubMed
Publication types
MeSH terms
LinkOut - more resources
Full Text Sources
Medical
Research Materials
Miscellaneous
